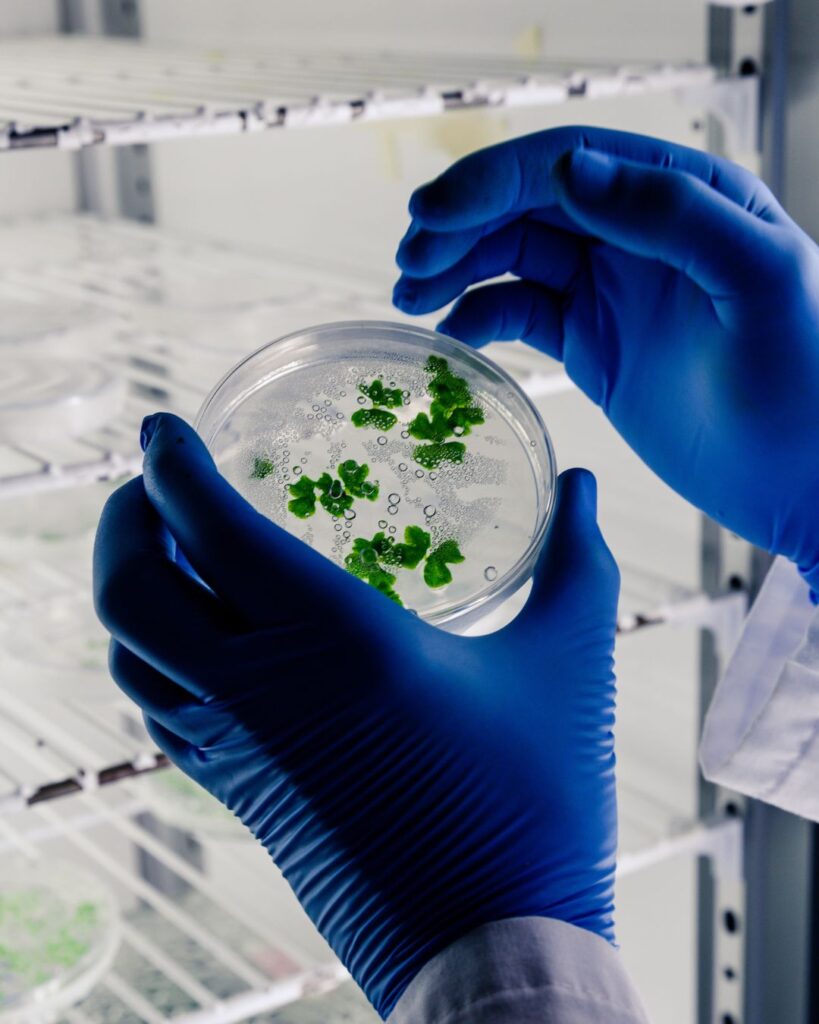
Career opportunities in Europe

Do you want to work somewhere where opportunity and innovation collide? Europe provides access to a world of excellent living standards, cultural diversity, and career advancement. Every skilled professional will find the ideal fit in Ireland’s tech-driven economy or Germany’s thriving engineering sector.
We at Esse India assist you in finding Career opportunities in Europe that fit your goals, abilities, and way of life. From locating the ideal High-Demand European Jobs to obtaining visa assistance and moving, our professional advice guarantees a seamless transition. Career opportunities in canada.
Your professional aspirations become a reality with Esse India’s dependable experience and in-depth understanding of European job markets. Today, let’s start the process of developing your international career in Europe.
This is where your European career journey begins. Best immigration consultants in New Delhi
The European Economic Landscape: Why Now is the Time

A new era of development and change is upon Europe. Now is a great time to look into career opportunities in Europe because of its balanced lifestyle and changing economy. Key trends influencing the region’s job market are creating new opportunities for skilled workers as well as long-term stability.Universities in Europe.
Driving Forces of Demand
The ageing population, or demographic shift
The need for qualified workers in engineering, technology, and healthcare is being exacerbated by Europe’s ageing population. Industries are making room for international talent to fill important positions and maintain productivity and innovation as more workers retire. Benefits of studying abroad.
The Green and Digital Shift
European nations are quickly transitioning to an eco-friendly and digital economy. Jobs in data science, IT, sustainability, and renewable energy are expanding more quickly than ever before. Governments are making significant investments in digital transformation initiatives, smart infrastructure, and clean energy.
Policies Regarding Immigration
Many European countries are streamlining immigration procedures in response to skill shortages. International professionals find it simpler to work, settle, and establish long-term careers across several EU member states thanks to programs like the EU Blue Card. Best Study abroad consultants in India.
B. Salary vs. Quality of Life
- Leaders in Salary: Strong social benefits and competitive salaries are provided by nations like Sweden, the Netherlands, and Germany. They offer professionals great value when paired with safe working conditions and Career opportunities in Europe for professional growth.
- Balance between work and life: Europe is renowned for its balanced lifestyle, which includes laws that are friendly to employees, paid vacations, and shorter workweeks. Europe is one of the most alluring places for job seekers from around the world because of the balance between income and quality of life.
The Top 10 High-Demand & Highest-Paying Sectors in Europe 2025

Rapid technological advancements, an ageing population, and a strong emphasis on sustainability are the defining features of the European labour market in 2025. These elements have raised the need for experts in particular fields, creating profitable job opportunities. An outline of the top 10 most Career opportunities in Europe lucrative and in-demand industries in Europe is provided below, along with information on key positions and average yearly salaries. why indian students choose to study abroad.
| Sector | Average Annual Salary (EUR) | Key Roles | Why It’s In-Demand |
| Healthcare & Biotechnology | €80,000 – €300,000+ | Surgeons, Dentists, Medical Directors | An ageing population and increased healthcare needs drive demand. |
| Artificial Intelligence (AI) | €70,000 – €150,000+ | AI Engineers, Data Scientists, ML Specialists | Rapid digital transformation and AI integration across industries. |
| Finance & Investment Banking | €100,000 – €675,000 | Investment Bankers, Financial Analysts, CFOs | Strong financial hubs like Frankfurt and Zurich attract top talent. |
| Software & IT Engineering | €70,000 – €130,000 | Software Engineers, IT Managers, Cybersecurity Experts | High demand for tech professionals in various industries. |
| Renewable Energy & Sustainability | €60,000 – €120,000 | Renewable Energy Engineers, Sustainability Consultants | The EU’s commitment to net-zero emissions by 2050 fuels sector growth. |
| Legal & Corporate Law | €80,000 – €150,000 | Corporate Lawyers, Legal Advisors, Patent Lawyers | Complex regulatory environments increase demand for legal expertise. |
| E-Commerce & Logistics | €50,000 – €100,000 | E-Commerce Managers, Supply Chain Analysts, Logistics Coordinators | Growth in online retail and global trade logistics. |
| Education & Research | €40,000 – €100,000 | University Professors, Researchers, Tutors | Emphasis on innovation and knowledge-driven economies. |
| Construction & Engineering | €50,000 – €100,000 | Civil Engineers, Project Managers, Architects | Infrastructure development and urbanisation projects across Europe. |
| Sales & Marketing | €40,000 – €90,000 | Digital Marketers, Sales Directors, Brand Managers | Shift towards digital marketing and customer-centric strategies. |
Healthcare & Biotechnology
The biotechnology and healthcare industries are expanding quickly, providing a wide range of Career opportunities in Europe and creative answers to pressing global issues. This field blends science, technology, and compassion to improve lives through everything from creating new medications to improving medical devices. Professionals can work in a variety of capacities in pharmaceutical development, clinical trials, research, and healthcare administration.
Thanks to robust research infrastructure, encouraging policies, and thriving biotech hubs, Europe in particular offers promising opportunities for talented individuals. Understanding cutting-edge technologies like gene therapy, personalised medicine, and AI-driven diagnostics is crucial for anyone hoping to work abroad. The industry keeps growing, generating impactful, long-lasting jobs. Indeed, aspirational professionals from all over the world are finding that career opportunities in biotechnology and healthcare in Europe are becoming more and more alluring.
Career Paths & Important Highlights:
- Research Scientist: Create novel medications, treatments, and medical equipment.
- Clinical Trial Manager: Manage studies to guarantee adherence to safety regulations.
- Create tools and procedures for the manufacturing of biopharmaceuticals as a biotech engineer.
- Healthcare Data Analyst: Enhance patient care with analytics and artificial intelligence.
- Regulatory Affairs Specialist: Make sure that biotech and medical standards are followed.
- Medical Sales & Marketing: Reach out to clinics and hospitals with biotech products and solutions.
Artificial Intelligence (AI)

The way we work and live is being altered by artificial intelligence (AI). It enables machines to carry out operations like language comprehension, pattern recognition, and decision-making that typically call for human intelligence. AI is used in everything from sophisticated analytics in businesses to smart assistants like Alexa and Siri. IT & Engineering Jobs in Europe.
In addition to increasing productivity, it creates opportunities for new sectors and occupations. Career options in data analysis, machine learning, AI development, and other fields are available to professionals and students. AI is a developing field with a wide range of roles that has a big impact on career opportunities in Europe if you’re thinking about global Career opportunities in Europe.
Important AI Points:
- AI facilitates decision-making and experience-based learning in machines.
- It is employed in transportation, education, healthcare, and finance.
- Voice assistants and chatbots driven by AI enhance consumer experiences.
- Data science, machine learning, and artificial intelligence skills are highly sought after.
- AI generates management, design, and research opportunities in addition to tech jobs.
- Global career advancement can be guided by an understanding of AI trends.
Finance & Investment Banking

The dynamic field of finance and investment banking is essential to money management, investment management, and business expansion. Experts in this field assist businesses with capital raising, merger advice, and investment guidance to optimise returns. The need for qualified finance professionals has increased dramatically as a result of globalisation, providing a wide range of career options.
Career opportunities in Europe for people with analytical abilities, market knowledge, and strategic thinking are numerous, ranging from investment bankers to financial analysts and portfolio managers. This industry provides global exposure in addition to high compensation for those looking to advance. Finance and investment banking is a promising field with a lot of room for learning and career advancement if you’re looking into career options in Europe.
Important Career Routes in Investment Banking and Finance:
- Investment bankers provide advice on capital raising, mergers, and acquisitions.
- Financial Analyst: Assesses financial information to direct investments.
- Portfolio Manager: Oversees investment portfolios for organisations or individuals.
- Risk analysts evaluate financial risks and create plans to reduce them.
- Corporate Finance Expert: Assists businesses with strategic financial planning and funding.
- Wealth Manager/Advisor: Assists customers in efficiently managing their personal or business wealth.
Software & IT Engineering

One of the most exciting and fulfilling professions nowadays is software and IT engineering. It provides a range of positions for competent professionals, from managing intricate IT systems to coding and application development. Companies in Europe and around the world are looking for specialists to create creative solutions, improve cybersecurity, and oversee cloud infrastructures because technology is changing so quickly.
Gaining knowledge of the newest tools, trends, and programming languages can greatly advance your career development, regardless of your level of experience. There are numerous career options in this field in Europe for prospective employees, including software development, IT consulting, data analysis, and system management. These positions offer competitive pay, exposure to other countries, and Career opportunities in Europe for professional growth.
Principal Aspects of IT and Software Engineering:
- Various positions include cloud engineer, cybersecurity specialist, IT analyst, and software developer.
- Industry Demand: There is a high demand from tech startups, e-commerce, healthcare, and finance.
- Global Exposure: The chance to collaborate on projects and teams with people from around the world.
- Development of Skills: Ongoing education in cloud, security, AI, and programming.
- Career advancement: Straightforward routes from junior developer to IT manager or CTO.
- Impact & Innovation: Help shape everyday life with cutting-edge technology.
Renewable Energy & Sustainability

The world’s power production and consumption patterns are changing due to sustainability and renewable energy. Clean energy solutions, such as solar panels and wind turbines, lower pollution, save resources, and improve the environment over time. Designing cities, industries, and lifestyles that preserve the environment while promoting economic growth is what sustainability is all about.
The need for qualified professionals is rising as a result of governments and businesses making significant investments in green projects. Green technology development, environmental consulting, sustainable design, and renewable energy projects are all promising Career opportunities in Europe for students and job seekers.
Crucial Points:
- Wind, solar, hydro, and biomass are examples of renewable energy sources.
- Sustainability is about conserving natural resources and lowering carbon footprints.
- Governments all over the world are providing incentives for environmentally friendly projects.
- Globally and in Europe, the number of jobs in green energy is increasing.
- In order to be sustainable, businesses require engineers, analysts, researchers, and project managers.
- Long-term pollution and energy expenses are decreased by using renewable energy.
Legal & Corporate Law

Commercial regulations, corporate structures, and business operations are governed by legal and corporate law. It guarantees businesses abide by national and international laws, safeguards stakeholders, and effectively settles conflicts. Experts in this area provide advice on corporate governance, labour laws, intellectual property, contracts, mergers, and acquisitions. The range is extensive, ranging from positions as in-house counsel at multinational corporations to working in law firms.
The need for legal professionals who understand cross-border regulations is increasing as a result of globalisation. Legal & Corporate Law provides opportunities for competitive growth and dynamic roles for those who are interested in law and business. For individuals looking for career opportunities in Europe, where corporate regulations and business law expertise are highly valued, investigating this sector holds particular promise.
Important Points in Corporate and Legal Law:
- Giving businesses advice on corporate governance, compliance, and contracts
- Managing issues related to intellectual property, mergers, and acquisitions
- Support for risk management and regulatory compliance
- Positions of in-house counsel in multinational firms
- Opportunities in advisory services, consulting, and law firms
- settling conflicts and defending companies in court
- Increasing need for cross-border legal knowledge
E-Commerce & Logistics

E-commerce has expanded quickly, and smooth online shopping is largely dependent on effective logistics. Logistics, from warehouses to last-mile delivery, guarantees that goods arrive at customers’ locations on schedule, preserving their satisfaction and confidence. To keep up with the increasing demand, businesses are investing in automated warehousing, tracking technologies, and smart supply chain management as a result of the growth of digital platforms.
This industry has a lot of promise for professionals. Diverse positions in supply chain management, inventory control, transportation planning, and e-commerce operations are available to those looking into career opportunities in Europe. This is a dynamic and changing industry where skills in data analysis, digital tools, and customer service are highly valued.
Important Aspects of Logistics and E-Commerce:
- A more efficient delivery process enhances the client experience.
- increasing need for qualified supply chain and logistics specialists.
- warehouse and inventory management powered by technology.
- Opportunities in digital supply chain tools, order fulfilment, and transportation.
- Predictive logistics integration with AI and data analytics.
- In European e-commerce markets, career growth is increasing.
Education & Research

Research and education are the cornerstones of advancement, creativity, and individual development. While research opens doors to finding new solutions and developing industries, receiving a high-quality education equips students with practical knowledge and critical thinking abilities. Professionals and students can obtain a competitive advantage in the global labour market by concentrating on both.
Strong academic and research experience frequently boosts employability, networking opportunities, and access to cutting-edge projects for individuals looking into career opportunities in Europe. People can stay ahead by working with experts, taking part in international programs, and understanding global trends. Making curiosity and lifelong learning a priority guarantees both professional and personal development.
Principal Points of Interest:
- access to top-notch instruction and cutting-edge research initiatives globally.
- chances to hone critical thinking, creativity, and problem-solving abilities.
- improved opportunities for employment in international corporations.
- exposure to international norms and procedures in a range of sectors.
- connecting with peers and experts in order to work together in the future.
- training for specialised positions in industries that rely heavily on research.
Construction & Engineering

A key component of contemporary development, the engineering and construction industry shapes cities, infrastructure, and creative projects all over the world. From project managers overseeing major developments to civil engineers designing bridges, professionals in this field enjoy a variety of roles. The industry offers dynamic work environments and long-term growth potential due to ongoing technological advancements like smart buildings, green construction, and sustainable engineering practices.
Due to the robust infrastructure projects and high demand for qualified engineers, investigating career opportunities in Europe can be especially fulfilling for individuals seeking to broaden their horizons. Construction and engineering offer a strong career path, regardless of your area of expertise—design, project management, or technical supervision.
Important Aspects & Career Points:
- Positions in mechanical, electrical, structural, and civil engineering are among them.
- Opportunities in quality control, planning, and project management.
- exposure to cutting-edge building technologies and environmentally friendly options.
- There is a great need for qualified workers both in Europe and abroad.
- competitive pay and room for long-term professional advancement.
- the opportunity to work on significant commercial, residential, and infrastructure projects.
Sales & Marketing

The key components of any successful business are marketing and sales. Marketing creates brand awareness and links products with the appropriate audience, whereas sales concentrates on closing deals and making money. To effectively accomplish goals, experts in this field employ tactics like customer analytics, social media outreach, and digital campaigns.
This field offers a variety of positions for individuals seeking career advancement, ranging from brand managers and digital strategists to sales executives and marketing coordinators. Due to the expansion of global business, Europe offers a wide range of Career opportunities in Europe that include exposure to international markets, skill development, and competitive salaries. A fulfilling and exciting career path can be accessed with a solid grasp of digital tools and consumer behaviour.
Important Aspects of Careers in Sales and Marketing:
- Sales executives, marketing coordinators, digital strategists, and brand managers are among the positions.
- Prioritise revenue generation, brand expansion, and customer engagement.
- Opportunities to work with digital campaigns, analytics, SEO, and social media.
- high demand throughout Europe, providing exposure worldwide and opportunities for professional advancement.
- The skills acquired can be applied to different industries and nations.
- Positions in management and leadership can result from strong performance.
- Long-term success is improved by ongoing learning about trends and technology.
Career Opportunities in Europe: Top 10 Destinations for Indians
With its robust economies, inventiveness, and international work cultures, Europe provides Indians with a wide range of Career opportunities in Europe. While Ireland and the Netherlands draw talent in technology and innovation, universities in germany stands out among all nations as a powerhouse with unparalleled industrial and IT sectors. Switzerland has a great standard of living and high salaries. Your industry preference, language comfort level, and career goals will all play a role in your decision. The top ten European nations for Indians looking for advancement, international recognition, and fulfilling careers are clearly compared here.
| Country | Why it’s #1 / Popular | Key Insight |
| Germany | Powerhouse for industries and IT | Largest economy in Europe, strong demand for engineers and IT professionals |
| Ireland | The Tech Hub | Home to major tech giants like Google & Facebook, English-speaking environment |
| Netherlands | Innovation & English-Friendly | Thriving startups, innovation-driven, English widely used in workplaces |
| Switzerland | High-paying jobs | Top salaries in finance, pharma, and tech, excellent work-life balance |
| Sweden | Sustainable & Innovative | Focus on green tech and innovation, progressive workplace culture |
| Denmark | Work-life Balance | Flexible working hours, high quality of life, strong healthcare system |
| Norway | Energy & Engineering | Opportunities in oil, gas, and renewable energy sectors |
| France | Cultural & Economic Hub | Strong in luxury, aerospace, and IT sectors, diverse multinational firms |
| Belgium | Multinational Base | EU headquarters location, career growth in politics, law, and IT |
| Austria | Engineering & Finance | Robust job market in finance, engineering, and tourism sectors |
The Migration Roadmap: Securing Your Work Visa

It can be difficult to find a job in Europe at first, but with the correct road map, the process becomes clear and doable. There are specific visa pathways that help qualified professionals begin their European journey smoothly, regardless of whether they have already received a job offer or are still looking. A brief explanation of the primary authorities involved and how to obtain a Work Visa Europe is provided below. Career opportunities in Europe.
The EU Blue Card: The Gold Standard
What it is: For highly qualified professionals from non-EU nations, the EU Blue Card is a distinguished work and residency permit. With alluring long-term benefits, it enables them to live and work in an EU member state.
The PR Benefit: Blue Card holders are eligible to apply for permanent residence, which grants them the freedom to travel and work anywhere in Europe, after working in the EU for about 33 months (or 21 months if they are proficient in the language).
Important prerequisites:
- a legitimate employment contract or job offer from a company in the EU.
- a degree from a university or a comparable experience.
- earnings that are sufficient to qualify for a Blue Card on a national level.
The Job Seeker Visa Pathway
Important Examples: Two well-known nations that grant job seeker visas, which enable qualified workers to enter and find work within a set period of time, are Germany and Austria.
How it Works: You can stay in the country for six to twelve months with this visa in order to look for a Jobs in Europe for Indians that fits your qualifications. You can change to a residence visa or work permit after you find employment.
Conditions:
- verified credentials and evidence of in-demand skills.
- evidence of finances to back up your stay.
- a current passport and health insurance.
- For professionals who want to investigate career options in Europe without having a prearranged offer, this route is perfect.
The Critical Factor: Language
Even though English is widely used in professional settings throughout Europe, learning the language significantly increases your chances of finding employment and integrating into the community. Interviews, social life, and long-term settlement prospects can all be significantly impacted by even rudimentary proficiency.
Why It Is Important:
- makes you more employable.
- enhances your chances of obtaining a PR and converting your visa.
- strengthens ties in the community and at work.
Real-World Insight: Essential Skills & Cultural Adaptation
Real-world skills are just as important as formal qualifications in the rapidly evolving professional world of today. You can advance in your career more quickly if you know what skills employers require and how to adjust to different cultures. The secret to succeeding in a global workplace is to embrace cultural values and acquire contemporary skills, regardless of whether you intend to look into Career opportunities in Europe.
Must-Have Skills for 2025
Employers now seek a blend of technical and human-centered skills as the job landscape rapidly changes. You must prioritise skills that integrate technology, creativity, and emotional intelligence if you want to remain competitive and relevant.
Important Competencies to Develop:
- Digital literacy: Being at ease with analytics, AI tools, and online teamwork.
- Adaptability: The ability to pick up new skills and develop with emerging technologies.
- Critical Thinking: The capacity to resolve issues and reach wise conclusions.
- Communication Skills: Interaction across cultural boundaries, clarity, and respect.
- Empathy and Leadership: Leading groups with compassion and inclusivity.
- You’ll be able to adapt more quickly and thrive in international work settings with these abilities.
Navigating the Cultural Shift
Understanding more than just language is necessary when transitioning into international roles; timing, mindset, and values are also important considerations. Career opportunities in Europe, trust, and teamwork are all enhanced by embracing cultural diversity.
- Structure & Punctuality: Being on time demonstrates professionalism and respect. Structured work routines and dependability are particularly valued in European workplaces. Your reputation can be enhanced by establishing priorities and remaining consistent.
- Work-Life Separation: A lot of multinational corporations, particularly those in Europe, encourage a healthy balance between work and personal life. Effective time management increases productivity and mental health. Learn to take breaks and respect others’ downtime.
- These professional practices: combined with cultural awareness can help you become more flexible, self-assured, and prepared to succeed in any global workplace.
- Understanding more than just language is necessary: when transitioning into international roles; timing, mindset, and values are also important. Accepting cultural diversity enhances collaboration, confidence, and professional achievement.
- Structure and Punctuality: Being on time demonstrates professionalism and respect. Reliability and structured work routines are highly valued in European workplaces. You can improve your reputation by establishing priorities and being consistent.
- Work-Life Separation: A lot of multinational corporations, particularly in Europe, encourage a healthy balance between work and personal life. It increases productivity and mental health to learn how to properly manage your time, take breaks, and respect others’ downtime.
These professional practices, along with cultural awareness, can help you become more flexible, self-assured, and prepared to succeed in any global workplace.
Partner with Esse India: Your Guaranteed Pathway to Europe

Esse India is a reliable partner for success when it comes to establishing your ideal career abroad. We assist you in realising your European career goal thanks to our extensive knowledge of international job markets, immigration regulations, and visa procedures. From eligibility evaluation to final visa approval, our staff provides individualised advice to guarantee a stress-free, easy journey. Esse India’s established experience makes your journey easy, transparent, and outcome-driven, whether you’re looking for study options, career opportunities in Europe, or PR pathways.
Our Focus & Expertise:
- ten years of experience advising on international immigration and visas.
- committed professionals for study and employment programs in Europe.
- transparent procedure with no unstated fees.
- Real results are ensured by a 100% client-focused approach.
Complete Service Package:
- Assessment of profiles and documentation for visas.
- help with resumes and job searches.
- assistance with relocation and interview preparation.
- Advice on legal matters and settlements after arrival.
Conclusion
For entrepreneurs looking for international exposure, recent graduates, and experienced professionals, career opportunities in Europe offer enormous potential. Europe offers a wide range of employment opportunities with competitive pay, a high standard of living, and a good work-life balance, from financial hubs in Switzerland and Luxembourg to tech hubs in Germany and Ireland.
International talent finds it easier to establish long-term careers on the continent thanks to its hospitable immigration laws and skill-based visa programs. Europe is a continent of stability, growth, and opportunity, regardless of your preference for traditional or innovation-driven careers. You can achieve rewarding professional success and lead a fulfilling life in one of the most dynamic regions of the world by matching your skills with the appropriate nation and industry.
Explore More:
- universities in hong kong
- cities in Canada for students
- Universities in Netherlands
- Universities in Australia
- Universities in canada for indian students
FAQs
Which jobs are currently in the highest demand in Europe?
Industries such as engineering, green energy, healthcare, and information technology are flourishing throughout Europe. Because of skill shortages in the UK and EU, occupations like software developers, data analysts, nurses, civil engineers, and renewable energy specialists are in high demand.
Which European nations provide foreigners with the greatest employment prospects?
In terms of work-life balance, high salaries, and Career opportunities in Europe, Germany, the Netherlands, Ireland, Sweden, and Austria are at the top of the list. These nations also offer easy access to visas, such as the EU Blue Card and Job Seeker Visas, and robust employment markets for skilled migrants.
How can someone from India or outside the EU find employment in Europe?
Applying is possible via European job boards like Indeed Europe, LinkedIn, and EURES. Direct applications via employer websites are also accepted in many nations. Adapting your resume to European standards and concentrating on in-demand positions with sponsorship Career opportunities in Europe for visas are beneficial.
Does working in Europe require me to speak the local tongue?
Not all the time. English is used by many startups and multinational corporations, particularly in the tech and financial sectors. Learning the local tongue, such as French or German, however, greatly improves your chances of finding employment and integrating into society.
How does the EU Blue Card benefit skilled workers?
For highly qualified non-EU nationals, the EU Blue Card is a work and residency permit. In addition to providing quicker permanent residency and mobility throughout the Schengen area, it permits professionals to live and work in any participating EU nation.
How much does a skilled professional in Europe typically make?
Pay varies by industry and nation. In Western Europe, IT and engineering professionals typically make between €45,000 and €80,000 annually, while healthcare and finance specialists can earn over €90,000.
Can foreign students in Europe find employment once they graduate?
Indeed, after completing their studies, international graduates are permitted to remain and work in the majority of European nations. Post-study work visas, which last 12 to 24 months, are provided by countries like Germany and Ireland to assist students in adjusting to full-time employment.
How can I lawfully enter Europe to work?
Employer sponsorship, skilled worker programmes, and job seeker visas are your options. Every nation has its own immigration pathways. For instance, Portugal and Austria have made it easier for qualified professionals to find housing, while Germany provides a Job Seeker Visa.
Can someone without EU citizenship easily find employment in Europe?
Although competitive, it is feasible. Non-EU nationals must apply for special visas like the EU Blue Card or obtain a job offer that satisfies skill and salary requirements. Your chances are increased by having relevant experience, fluency in English, and strong qualifications.
Which European industries have the most room to grow in the future?
Artificial intelligence, cybersecurity, biotechnology, renewable energy, and sustainable engineering are examples of emerging fields. These sectors provide long-term job stability and advancement because of Europe’s emphasis on digital transformation and green innovation.




